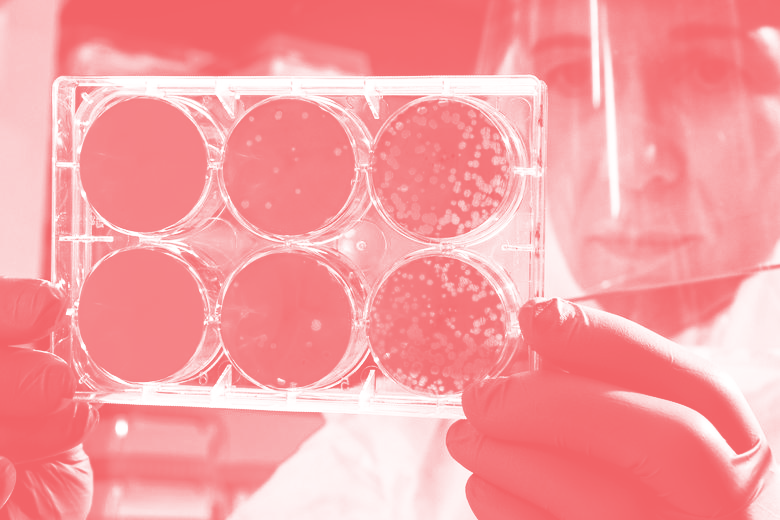

Responses to the UK COVID-19 Challenge Studies:
“In a pandemic, time is lives. So far, over a million people have died.
“There is a moral imperative to develop to a safe and effective vaccine – and to do so as quickly as possible. Challenge studies are one way of accelerating vaccine research. They are ethical if the risks are fully disclosed and they are reasonable. The chance of someone aged 20-30 dying of COVID-19 is about the same as the annual risk of dying in a car accident. That is a reasonable risk to take, especially to save hundreds of thousands of lives. It is surprising challenge studies were not done sooner. Given the stakes, it is unethical not to do challenge studies.”
Prof Julian Savulescu, Uehiro Chair in Practical Ethics, and Director of the Oxford Uehiro Centre for Practical Ethics, and Co-Director of the Wellcome Centre for Ethics and Humanities, University of Oxford
“Human challenge studies are an important and powerful research tool to help accelerate our understanding of infectious diseases and vaccine development. They have been used for many years for a range of different infections.
“The announcement of the UK Human Challenge Program is a vital step forward for the UK and the world in our shared objective of bringing the COVID-19 pandemic to an end. With cases climbing across Europe, and more than 1.2 million deaths worldwide, there is an urgent ethical imperative to explore and establish COVID-19 challenge trials.
“All research needs ethical safeguards. Challenge trials need to be carefully designed to ensure that those who take part are fully informed of the risks, and that the risks to volunteers are minimised. Not everyone could take part in a challenge trial (only young, healthy volunteers are likely to be able to take part). Not everyone would choose to take part. But there are hundreds of young people in the UK and elsewhere who have already signed up to take part in COVID challenge studies. They deserve our admiration, our support and our thanks.”
Prof Dominic Wilkinson, Professor of Medical Ethics, Oxford Uehiro Centre for Practical Ethics, University of Oxford
Further Research
Read more about the ethics of challenge studies:
Read More »Press Release: UK Approves COVID-19 Challenge Studies